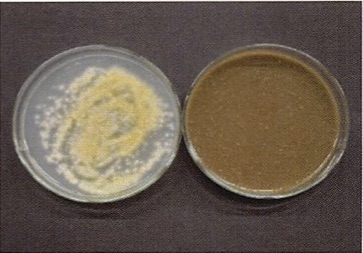
い草には水虫の原因となる白癬菌や、足の臭いの原因となる微生物、また大腸菌O157などに対して抗菌効果があります。

国産いぐさの「チカラ」
-
【空気浄化】 スポンジ構造が有害物質を吸着
-
い草は人工的な敷物に比べ、シックハウスの原因と言われる「ホルムアルデヒド」や「二酸化窒素」の吸着に優れています。
ホルムアルデヒド(大阪府立産業技術研究所認定試験)
-
【保温・断熱性】 冬でも温かい
-
い草のスポンジ構造により調湿効果も抜群です!
高温多湿な日本の夏にゴロリと横になっても気持ち良く、人工的な敷物より優れた機能です。
-
【調湿効果】 夏にゴロリと横になっても気持ちいい
-
い草のスポンジ構造により調湿効果も抜群です!高温多湿な日本の夏にゴロリと横になっても気持ち良く、人工的な敷物より優れた機能です。
-
【抗菌効果】 白癬菌や大腸菌O157など
-
い草には水虫の原因となる白癬菌や、足の臭いの原因となる微生物、また大腸菌O157などに対して抗菌効果があります。
い草の抗菌効果は以下のとおりです。
- サルモネラ菌(食中毒細菌)
- 黄色ブドウ球菌(食中毒細菌)
- 腸管出血性大腸菌O157(食中毒細菌)
- 腸管出血性大腸菌O26(食中毒細菌)
- 腸管出血性大腸菌O111(食中毒細菌)
- バチルス菌(腐敗細菌)
- ミクロコッカス菌(腐敗細菌)
- 白癬菌(水虫の原因となるカビ)
- 足の臭いの原因となる微生物群
- レジオネラ菌
(2020年 畳表アドバイザー 森田教授 講演会資料より)
-
【睡眠効果・リラックス効果】 国産い草の良さは香り
-
国産い草の優位性の1つに「香り」があげられます。この「い草の香り」は、森林浴のようにリラックス効果や睡眠効率を向上させる効果があることが九州大学の研究により立証されました。
リラックス効果
リラックス時に増大する脳波のα(アルファ)波の実験結果で、国産い草と人工的な敷物と比較したグラフです。この結果より、い草にはリラックス効果がある事を表しています。
安眠効果
人工的な敷物と比較して睡眠効率が高かった事を表しています。(データは九州大学調査。本研究(調査結果)は農研機構生研支援センター「革新的技術開発・緊急展開事業(地域戦略プロジェクト)」の支援を受けて実施した)
-
【集中力アップ】 子どもの教育に朗報
-
北九州市立大学森田博士の研究で「畳部屋における学習効果」について発表され「畳教室には集中力持続効果がある」ことが明らかになりました。
畳教室で解答するほうが、解答率が約14.4%増加。正解率に差がなく、解答数が伸びたことで、畳部屋における集中力持続効果が認められました。
北九州市立大学森田博士の研究
畳教室と一般教室において、簡単な算数の問題をそれぞれ30分ずつ解かせて結果を比較してみました。
※英進館に所属の中学1年生及び小学5年生の323名(男性:196名/女性127名が対象)
畳の教室で勉強した伸び率については下記のとおりでした。(一般教室の結果を100として)
※有効回答/中学1年生・小学5年生260名(男性157名/女性103名)
環境にもやさしい
世界中でプラスチックごみへの関心が急速に高まっています。海洋生物が体内に取り込んだマイクロプラスチックは細かな粒子であり、分解されないため体内に蓄積されている可能性があります。次世代にも自然豊かな地球環境を引き継ぎたいものです。
熊本県産畳表は天然いぐさで織られ、経糸も綿または麻糸を使用し、すべて土に還る素材でできています。製造過程でも、天然の泥で染めており化学的な着色剤などは使用されず、人や地球環境にもやさしい敷物です。
廃棄時には、自然に還る
畳表だけであれば自然素材のため、そのまま雨ざらしにすると微生物が分解して土に還してくれます。工業製品のように廃棄するとき環境に負担をかけることなく処分できます。
製造時のエネルギー負荷が少ない
自然素材は工業製品と比べると、製品化するときに使用するエネルギーは一般に少ないと言われます。自然界に存在している時に形は出来上がっており、あとは加工をするだけであり、環境負担を減らすことができます。
国産いぐさのプロが語る
国産いぐさのプロが語る、説得力満載のエピソード。
当時104歳の祖母が国産の畳の上で転んだのですが、無傷だったんです
104歳になる祖母が、国産の畳のうえで転んでしまったのですが、骨が折れることもなく、無事でした。
国産の畳は、内部に無数の空気層があるんです。これは、国産のいぐさの海面構造のおかげ。独特の緩衝効果が、祖母を救ってくれました。もちろん、赤ちゃんにもおすすめです。国産の畳がある環境で育つと、集中力がアップするという実証データもあるくらい。
この空気層、実は調湿効果もあるんです。
余分な湿度を吸収し、空気が乾燥した場合には海綿質に蓄えた水分を放湿してくれます。暑い夏は、室内の湿度を下げ、空気が乾燥する冬は加湿してくれるんですよ。
国産の畳は、シックハウス症候群の原因になる「ホルムアルデヒド」などの有害物質も吸収してくれますし、さまざまな有害微生物に対する抗菌作用も持っているので、最近多くなってきた「気密性が高い住宅」にもおすすめです。
香りもいいですよね。
この香りの成分「バニリン」には心を落ち着かせる効果があると言われています。
日本は「古事記」の頃から畳とともに暮らしてきた
「古事記」の頃から使われていた「畳」。現在の畳に似た構造になったのは平安時代で、高貴な人や客人のおもてなしのために用いられ、畳の厚さやフチの柄、色は買う人の身分によって異なったと言われています。
庶民が使えるようになったのは江戸時代中期以降で、畳屋さんは大活躍でした。
国産いぐさ作付け面積の95%が熊本産
室町時代からいぐさ栽培を行っている熊本県。県内で染土を統一し、着色剤の使用を禁止しているため、泥染め後の色調は美しく、この泥が赤ちゃんの肌にベビーパウダーを塗るような役割をすることで、表面が保護され、均一に、いっぺんに水分を飛ばすことができます。
この他にも、国産の畳の良さを維持するために、さまざまな取り組みが行われています。
よく「深緑だったのが黄色くなってしまった」という声を聞きますが、これは「天然だからこそ」なんです。いぐさは「草」ですから、色が変わるのは当たり前。飴色に変化していく風合いはとても美しく、そこを楽しむのも醍醐味です。
国産のいぐさは、成育時に厳しい農薬管理使用規程や泥染めの泥の成分規定・着色料や防ダニ/防カビ加工の制限など、『安心・安全』には万全の取り組みが行われています。これが、高い品質につながっています。
国産の畳は、簡単な日常のお手入れで、とても長持ちします。
また、「裏返し」「畳替え」もできるため、耐用年数は驚くほど長いんです。
「裏返し」とは言葉のとおりで、畳表(ござ)はリバーシブル。裏返しにすることで、再び新畳のような感触を味わうことができます。「畳替え」は、畳そのものを替えることです。
古来より愛され、多くの人々に使われてきた国産の畳は、「日本人らしさ」といううえでも最高の敷物といえるでしょう。